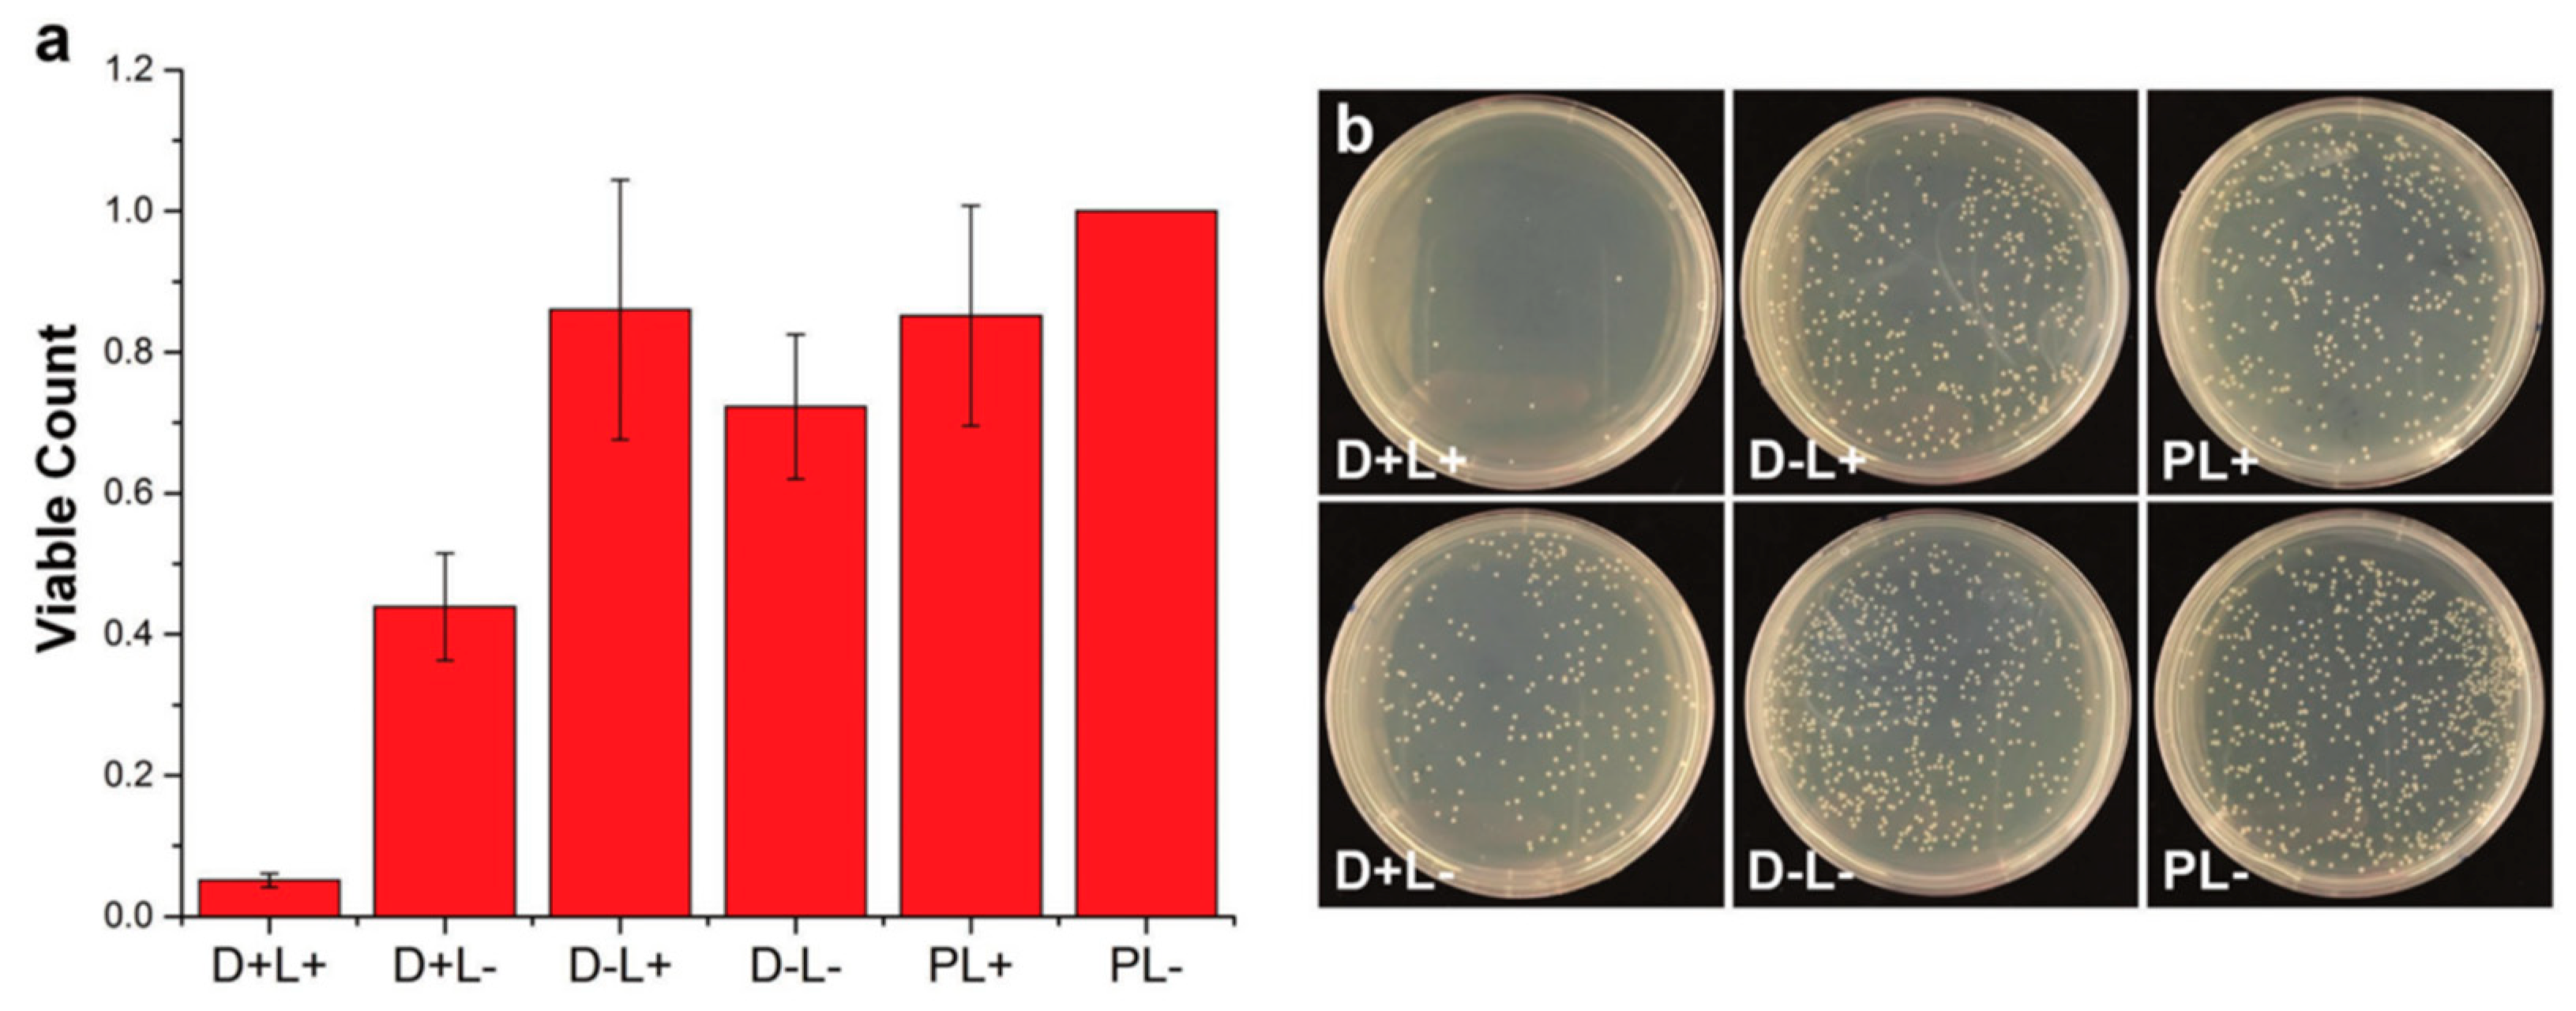
Ijms 20 01210 g006
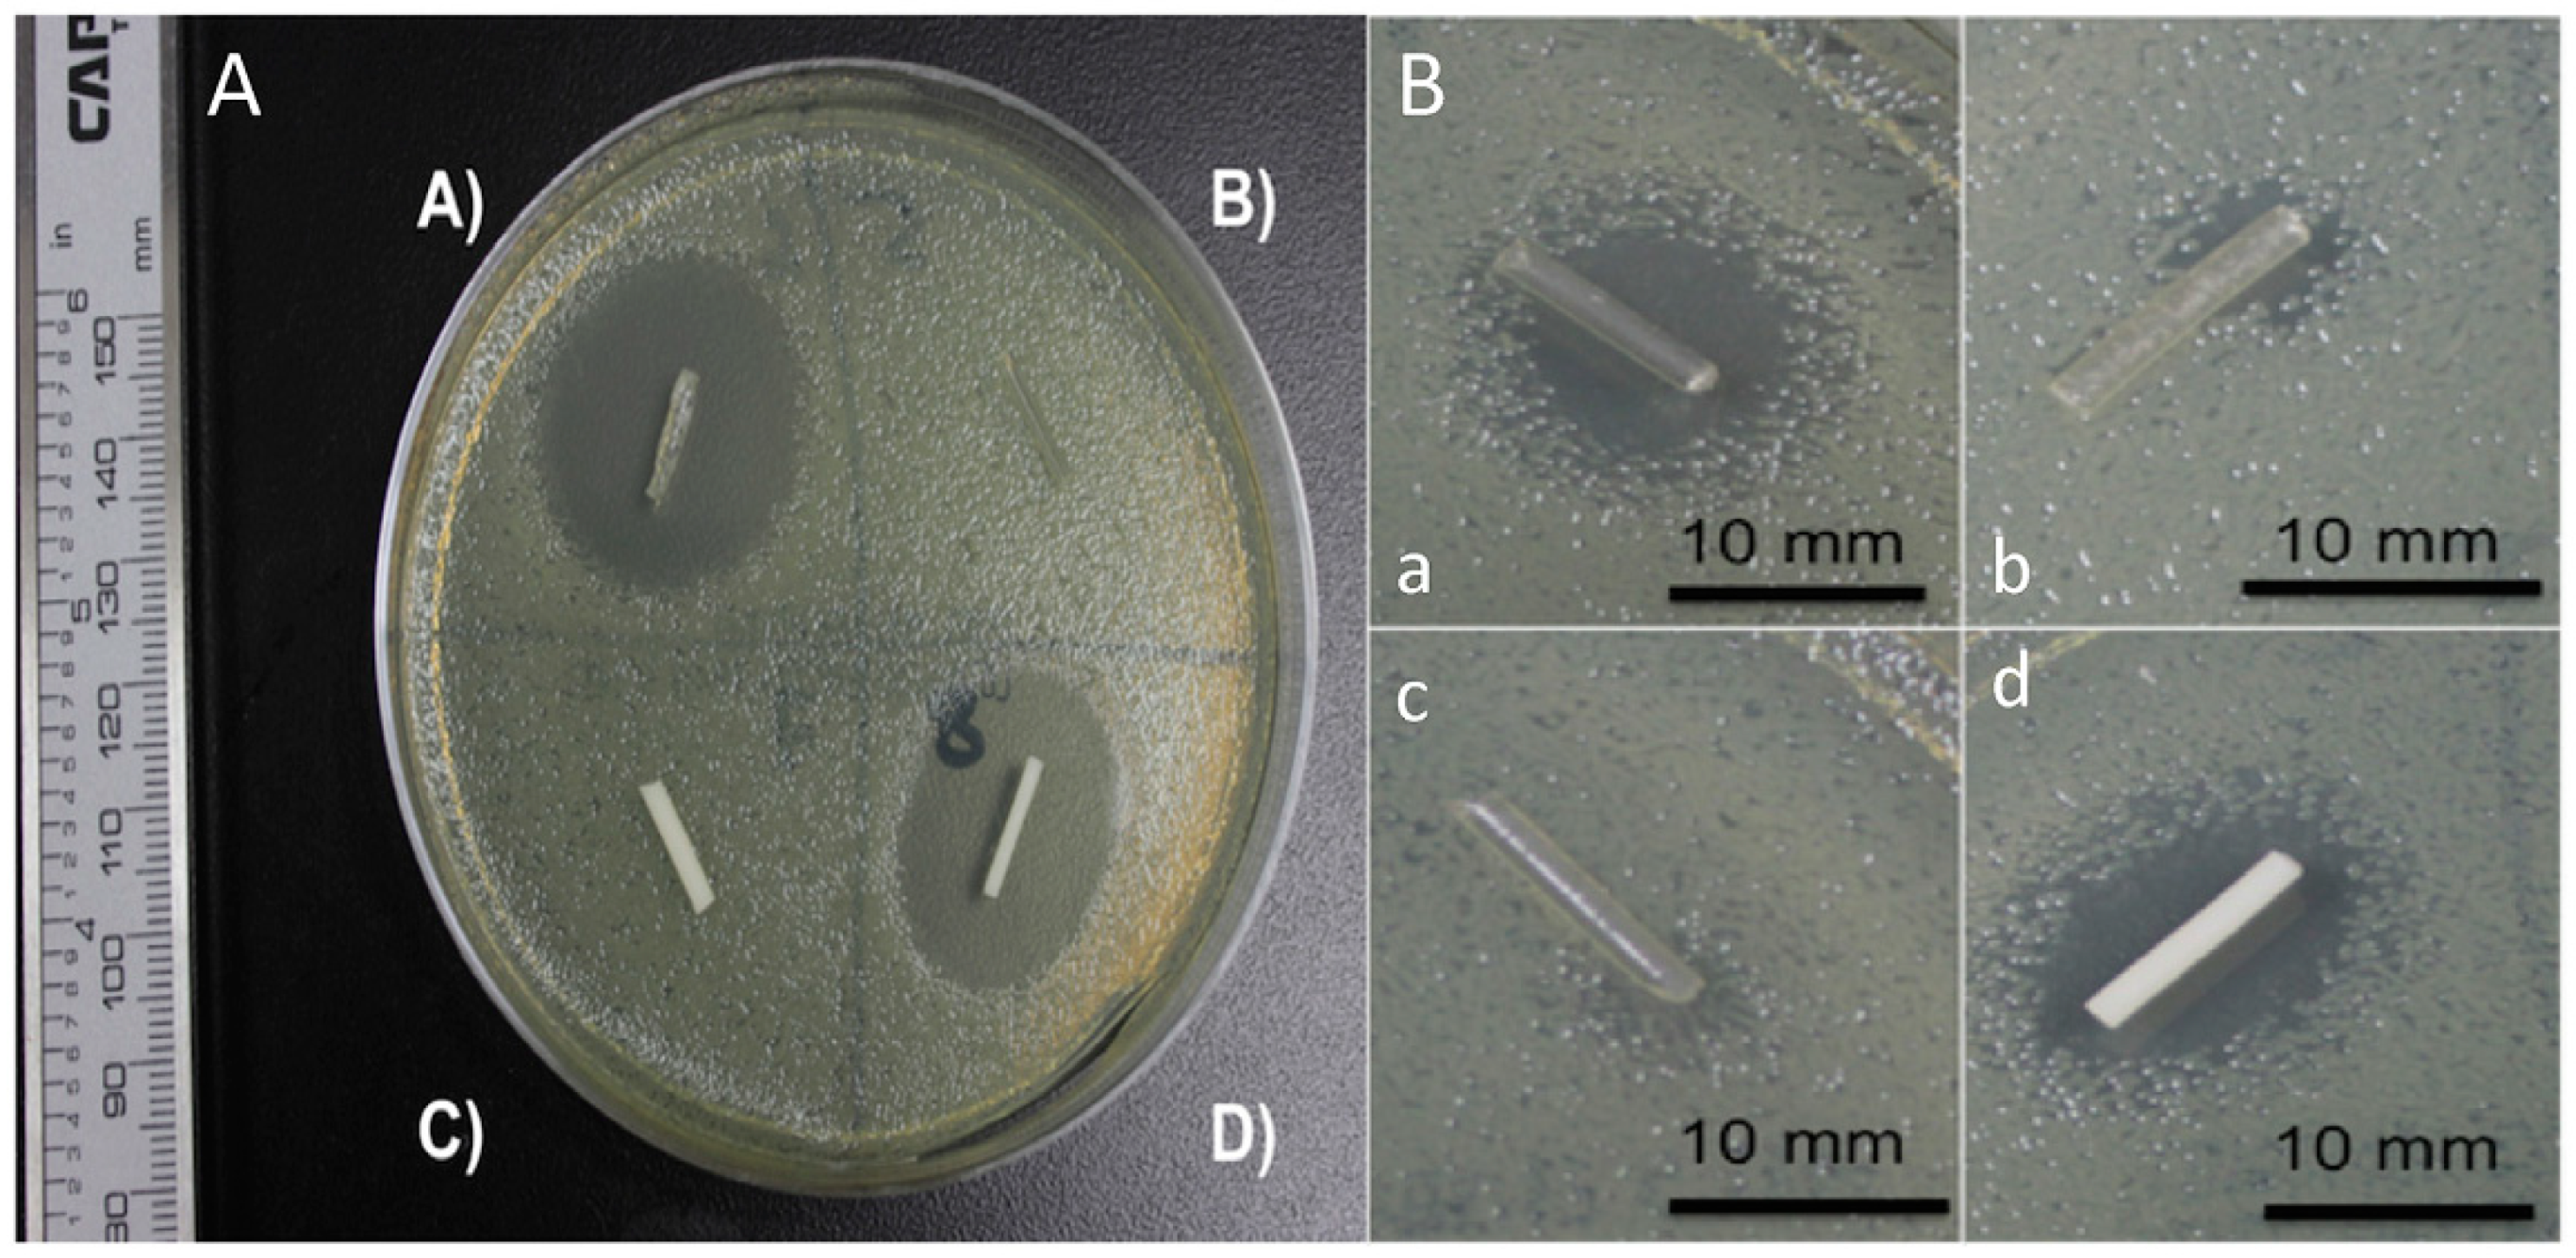
Ijms 20 01210 g012

Antimicrobial Polymers for Additive Manufacturing
Abstract
:1. Introduction
2. Principles of Additive Manufacturing
3. Innovative AM Technologies
4. Antibacterial Polymers: Few Elementary Aspects
4.1. Polymer Requirements: Polymeric Structures and Other Relevant Characteristics
- (a)
- able to establish enough contact with the microorganisms,
- (b)
- the polymer should have enough cationic groups so that the adhesion to the microorganism cell can occur,
- (c)
- the polymer should also be designed with hydrophobic moieties that are responsible for the attachment and integration inside the cellular membrane.
- (d)
- the polymer must selectively kill the microbes in the presence of other cells such as mammalian cells.
- (1)
- be synthesized using easy and cost-effective strategies
- (2)
- be stable for the applications that can in some cases require long-term usage and storage at a certain temperature
- (3)
- the polymer should remain insoluble in aqueous solution
- (4)
- not decompose or release toxic products, and should not be toxic or irritating to users
- (5)
- ideally be regenerated, maintaining its activity, and finally,
- (6)
- be able to target different pathogenic microorganisms in a relatively short period of time.
4.2. Types of Antimicrobial Groups Integrated in Polymers
4.2.1. Positively Charged Functional Groups
4.2.2. Other Antimicrobial Functional Groups
4.3. Macromolecular Characteristics and their Role in the Antibacterial Activity
5. Antimicrobial Polymers, Blends, and Composites in Additive Manufacturing
6. Naturally Occurring Antimicrobial Polymers
7. Synthetic Polymers with Bactericidal Properties
7.1. Antimicrobial Functional Monomers as Components in SLA Resins
7.2. Antimicrobial Polymers for FDM
7.3. Surface Modification (Patterning and Functionalization) of 3D Printed Parts
8. 3D Printed Polymeric Composites with Antibacterial Capacities
9. Conclusions
Author Contributions
Funding
Acknowledgments
Conflicts of Interest
References
- Gibson, I.; Rosen, D.; Stucker, B. Introduction and Basic Principles in Additive Manufacturing Technologies; Springer New York: New York, NY, USA, 2015; pp. 1–18. ISBN 978-1-4939-2112-6. [Google Scholar]
- Campbell, T.A.; Ivanova, O.S. Additive Manufacturing as a Disruptive Technology: Implications of Three-Dimensional Printing. Technol. Innov. 2013, 15, 67–79. [Google Scholar] [CrossRef]
- Villar, G.; Graham, A.D.; Bayley, H. A Tissue-Like Printed Material. Science 2013, 340, 48–52. [Google Scholar] [CrossRef] [PubMed] [Green Version]
- Duarte Campos, D.F.; Blaeser, A.; Weber, M.; Jäkel, J.; Neuss, S.; Jahnen-Dechent, W.; Fischer, H. Three-dimensional printing of stem cell-laden hydrogels submerged in a hydrophobic high-density fluid. Biofabrication 2013, 5, 015003. [Google Scholar] [CrossRef] [PubMed]
- Guo, Q.; Cai, X.; Wang, X.; Yang, J. “Paintable” 3D printed structures via a post-ATRP process with antimicrobial function for biomedical applications. J. Mater. Chem. B 2013, 1, 6644–6649. [Google Scholar] [CrossRef]
- Sun, J.; Zhou, W.; Huang, D.; Fuh, J.Y.H.; Hong, G.S. An Overview of 3D Printing Technologies for Food Fabrication. Food Bioprocess Technol. 2015, 8, 1605–1615. [Google Scholar] [CrossRef]
- Kenawy, E.-R.; Worley, S.D.; Broughton, R. The Chemistry and Applications of Antimicrobial Polymers: A State-of-the-Art Review. Biomacromolecules 2007, 8, 1359–1384. [Google Scholar] [CrossRef] [PubMed]
- Sandler, N.; Salmela, I.; Fallarero, A.; Rosling, A.; Khajeheian, M.; Kolakovic, R.; Genina, N.; Nyman, J.; Vuorela, P. Towards fabrication of 3D printed medical devices to prevent biofilm formation. Int. J. Pharm. 2014, 459, 62–64. [Google Scholar] [CrossRef] [PubMed]
- Koo, H.; Yamada, K.M. Dynamic cell-matrix interactions modulate microbial biofilm and tissue 3D microenvironments. Curr. Opin. Cell Biol. 2016, 42, 102–112. [Google Scholar] [CrossRef] [PubMed] [Green Version]
- Jung, J.W.; Lee, J.S.; Cho, D.W. Computer-Aided multiple-head 3D printing system for printing of heterogeneous organ/tissue constructs. Sci. Rep. 2016, 6, 21685. [Google Scholar] [CrossRef] [PubMed]
- Melocchi, A.; Parietti, F.; Maroni, A.; Foppoli, A.; Gazzaniga, A.; Zema, L. Hot-melt extruded filaments based on pharmaceutical grade polymers for 3D printing by fused deposition modeling. Int. J. Pharm. 2016, 509, 255–263. [Google Scholar] [CrossRef] [PubMed]
- Berman, B. 3-D printing: The new industrial revolution. Bus. Horiz. 2012, 55, 155–162. [Google Scholar] [CrossRef]
- Sedacca, B. Hand built by lasers [additive layer manufacturing]. Eng. Technol. 2011, 6, 58–60. [Google Scholar] [CrossRef]
- Mawale, M.B.; Kuthe, A.M.; Dahake, S.W. Additive layered manufacturing: State-of-the-art applications in product innovation. Concurr. Eng. 2016, 24, 94–102. [Google Scholar] [CrossRef] [Green Version]
- Gausemeier, J.; Echterhoff, N.; Wall, M. Thinking ahead the Future of Additive Manufacturing—Analysis of Promising Industries; Direct Manufacturing Research Center, University of Paderborn: Paderborn, Germany, 2012; pp. 1–103. [Google Scholar]
- Inzana, J.A.; Trombetta, R.P.; Schwarz, E.M.; Kates, S.L.; Awad, H.A. 3D printed bioceramics for dual antibiotic delivery to treat implant-associated bone infection. Eur. Cells Mater. 2015, 30, 232–247. [Google Scholar] [CrossRef] [Green Version]
- Zhu, F.; Skommer, J.; Macdonald, N.P.; Friedrich, T.; Kaslin, J.; Wlodkowic, D. Three-dimensional printed millifluidic devices for zebrafish embryo tests. Biomicrofluidics 2015, 9, 046502. [Google Scholar] [CrossRef] [PubMed] [Green Version]
- Zhu, F.; Skommer, J.; Friedrich, T.; Kaslin, J.; Wlodkowic, D. 3D Printed Polymers Toxicity Profiling: A Caution for Biodevice Applications; Eggleton, B.J., Palomba, S., Eds.; International Society for Optics and Photonics: San Diego, CA, USA, 2015; p. 96680Z. [Google Scholar]
- Carve, M.; Wlodkowic, D. 3D-Printed Chips: Compatibility of Additive Manufacturing Photopolymeric Substrata with Biological Applications. Micromachines 2018, 9, 91. [Google Scholar] [CrossRef] [PubMed]
- Formlabs. SAFETY DATA SHEET: Clear Photoreactive Resin for Formlabs 3D Printers; Formlabs: Somerville, MA, USA, 2016. [Google Scholar]
- Sigma-Aldrich. SAFETY DATA SHEET: Diphenyl(2,4,6-trimethylbenzoyl)phosphine Oxide, version 5.4; Sigma-Aldrich: St. Louis, MO, USA, 2016. [Google Scholar]
- Bail, R.; Patel, A.; Yang, H.; Rogers, C.M.; Rose, F.R.A.J.; Segal, J.I.; Ratchev, S.M. The Effect of a Type I Photoinitiator on Cure Kinetics and Cell Toxicity in Projection-Microstereolithography. Procedia CIRP 2013, 5, 222–225. [Google Scholar] [CrossRef] [Green Version]
- Formlabs. SAFETY DATA SHEET: Dental LT Clear (Photoreactive Resin for Form 2); Formlabs: Somerville, MA, USA, 2017. [Google Scholar]
- Vertex Dental. SAFETY DATA SHEET: NextDent Ortho IBT; Vertex Dental: Zeist, The Netherlands, 2015. [Google Scholar]
- Anadón, A.; Bell, D.; Binderup, M.-L.; Bursch, W.; Castle, L.; Crebelli, R.; Engel, K.-H.; Gontard, N.; Haertlé, T.; Husøy, T.; et al. Toxicological evaluation of benzophenone. EFSA J. 2009, 7, 1–30. [Google Scholar]
- Sigma-Aldrich. SAFETY DATA SHEET: Benzophenone, version 3.12; Sigma-Aldrich: St. Louis, MO, USA, 2017. [Google Scholar]
- 3D Systems Inc. SAFETY SATA SHEETt: VisiJet SL Clear, ID: 24672-S12-04-A; 3D Systems Inc.: Rock Hill, SC, USA, 2016. [Google Scholar]
- DeltaMed. SAFETY DATA SHEET: E-Shell 600 Clear; DeltaMed: Friedberg, Germany, 2016. [Google Scholar]
- Autodesk-Inc. SAFETY DATA SHEET: Autodesk Resin: PR57-K-v.2 Black; Autodesk-Inc.: San Rafael, CA, USA, 2016. [Google Scholar]
- Dormer, W.; Gomes, R.; Meek, M. Concise International Chemical Assessment Document: Methyl Methacrylate; World Health Organization: Geneva, Switzerland, 1998. [Google Scholar]
- BASF CORPORATION. SAFETY DATA SHEET: Methyl Acrylate, version: 3; BASF CORPORATION: Ludwigshafen, Germany, 2016. [Google Scholar]
- Sigma-Aldrich. SAFETY DATA SHEET: Methyl Methacrylate; Version 5.4; Sigma-Aldrich: St. Louis, MO, USA, 2015. [Google Scholar]
- Sigma-Aldrich. SAFETY DATA SHEET: Methyl Acrylate; Version 3.9; Sigma-Aldrich: St. Louis, MO, USA, 2015. [Google Scholar]
- Schamazls, G.; Arenholt-Bindslev, D. Biocompatibility of Dental Materials; Springer: Berlin/Heidelberg, Germany, 2009; ISBN 978-3-540-77781-6. [Google Scholar]
- Sigma-Aldrich. SAFETY DATA SHEET: Butylated Hydroxytoluene, version 5.2; Sigma-Aldrich: St. Louis, MO, USA, 2014. [Google Scholar]
- Sigma-Aldrich. SAFETY DATA SHEET: 1-Bis(2,2,6,6-tetramethyl-4-piperidyl) Sebacate, version 4.4; Sigma-Aldrich: St. Louis, MO, USA, 2015. [Google Scholar]
- Sigma-Aldrich. SAFETY DATA SHEET: Hydroquinone, version 4.2; Sigma-Aldrich: St. Louis, MO, USA, 2017. [Google Scholar]
- Du, Y.; Wang, W.-Q.; Pei, Z.-T.; Ahmad, F.; Xu, R.-R.; Zhang, Y.-M.; Sun, L.-W. Acute Toxicity and Ecological Risk Assessment of Benzophenone-3 (BP-3) and Benzophenone-4 (BP-4) in Ultraviolet (UV)-Filters. Int. J. Environ. Res. Public Health 2017, 14, 1414. [Google Scholar] [CrossRef] [PubMed]
- Sigma-Aldrich. SAFETY DATA SHEET: Methacrylic Acid, version 4.7; Sigma-Aldrich: St. Louis, MO, USA, 2014. [Google Scholar]
- Manabe, K.; Nishizawa, S.; Shiratori, S. Porous Surface Structure Fabricated by Breath Figures that Suppresses Pseudomonas aeruginosa Biofilm Formation. ACS Appl. Mater. Interfaces 2013, 5, 11900–11905. [Google Scholar] [CrossRef] [PubMed]
- Bourell, D.L. Perspectives on Additive Manufacturing. Annu. Rev. Mater. Res. 2016, 46, 1–18. [Google Scholar] [CrossRef]
- Wang, J.-C.; Zheng, H.; Chang, M.-W.; Ahmad, Z.; Li, J.-S. Preparation of active 3D film patches via aligned fiber electrohydrodynamic (EHD) printing. Sci. Rep. 2017, 7, 43924. [Google Scholar] [CrossRef] [PubMed] [Green Version]
- Jonušauskas, L.; Gailevičius, D.; Mikoliunaite, L.; Sakalauskas, D.; Šakirzanovas, S.; Juodkazis, S.; Malinauskas, M. Optically clear and resilient free-form μ-optics 3D-printed via ultrafast laser lithography. Materials 2017, 10, 12. [Google Scholar] [CrossRef] [PubMed]
- Park, J.; Kim, K.-I.; Kim, K.; Kim, D.-C.; Cho, D.; Lee, J.H.; Jeon, S. Rapid, High-Resolution 3D Interference Printing of Multilevel Ultralong Nanochannel Arrays for High-Throughput Nanofluidic Transport. Adv. Mater. 2015, 27, 8000–8006. [Google Scholar] [CrossRef] [PubMed]
- Dolinski, N.D.; Page, Z.A.; Callaway, E.B.; Eisenreich, F.; Garcia, R.V.; Chavez, R.; Bothman, D.P.; Hecht, S.; Zok, F.W.; Hawker, C.J. Solution Mask Liquid Lithography (SMaLL) for One-Step, Multimaterial 3D Printing. Adv. Mater. 2018, 30, 1800364. [Google Scholar] [CrossRef] [PubMed]
- Watanabe, K.; Kinoshita, M.; Mine, T.; Morishita, M.; Fujisaki, K.; Matsui, R.; Sagawa, M.; Machida, S.; Oba, H.; Sugiyama, Y.; et al. Plasma ion-beam 3D printing: A novel method for rapid fabrication of customized MEMS sensors. In Proceedings of the 2018 IEEE Micro Electro Mechanical Systems (MEMS), Belfast, UK, 21–25 January 2018; pp. 459–462. [Google Scholar]
- Zhang, H.Z.; Zhang, F.T.; Zhang, X.H.; Huang, D.; Zhou, Y.L.; Li, Z.H.; Zhang, X.X. Portable, Easy-to-Operate, and Antifouling Microcapsule Array Chips Fabricated by 3D Ice Printing for Visual Target Detection. Anal. Chem. 2015, 87, 6397–6402. [Google Scholar] [CrossRef] [PubMed]
- Connell, J.L.; Ritschdorff, E.T.; Whiteley, M.; Shear, J.B. 3D printing of microscopic bacterial communities. Proc. Natl. Acad. Sci. USA 2013, 110, 18380–18385. [Google Scholar] [CrossRef] [PubMed] [Green Version]
- Steiner, H.; Hultmark, D.; Engström, Å.; Nature, H.B. Sequence and specificity of two antibacterial proteins involved in insect immunity. Nature 1981, 292, 246. [Google Scholar] [CrossRef] [PubMed]
- Wang, Z.; Wang, G. APD: The antimicrobial peptide database. Nucleic Acids Res. 2004, 32 (Suppl. 1), D590–D592. [Google Scholar] [CrossRef]
- Palermo, E.F.; Kuroda, K. Structural determinants of antimicrobial activity in polymers which mimic host defense peptides. Appl. Microbiol. Biotechnol. 2010, 87, 1605–1615. [Google Scholar] [CrossRef] [PubMed]
- Thoma, L.M.; Boles, B.R.; Kuroda, K. Cationic Methacrylate Polymers as Topical Antimicrobial Agents against Staphylococcus aureus Nasal Colonization. Biomacromolecules 2014, 15, 2933–2943. [Google Scholar] [CrossRef] [PubMed]
- King, A.; Chakrabarty, S.; Zhang, W.; Zeng, X.; Ohman, D.E.; Wood, L.F.; Abraham, S.; Rao, R.; Wynne, K.J. High Antimicrobial Effectiveness with Low Hemolytic and Cytotoxic Activity for PEG/Quaternary Copolyoxetanes. Biomacromolecules 2014, 15, 456–467. [Google Scholar] [CrossRef] [PubMed]
- Liu, R.; Chen, X.; Chakraborty, S.; Lemke, J.J.; Hayouka, Z.; Chow, C.; Welch, R.A.; Weisblum, B.; Masters, K.S.; Gellman, S.H. Tuning the Biological Activity Profile of Antibacterial Polymers via Subunit Substitution Pattern. J. Am. Chem. Soc. 2014, 136, 4410–4418. [Google Scholar] [CrossRef] [PubMed]
- Liu, R.; Chen, X.; Falk, S.P.; Mowery, B.P.; Karlsson, A.J.; Weisblum, B.; Palecek, S.P.; Masters, K.S.; Gellman, S.H. Structure–Activity Relationships among Antifungal Nylon-3 Polymers: Identification of Materials Active against Drug-Resistant Strains of Candida albicans. J. Am. Chem. Soc. 2014, 136, 4333–4342. [Google Scholar] [CrossRef] [PubMed]
- Stratton, T.R.; Applegate, B.M.; Youngblood, J.P. Effect of Steric Hindrance on the Properties of Antibacterial and Biocompatible Copolymers. Biomacromolecules 2011, 12, 50–56. [Google Scholar] [CrossRef] [PubMed]
- Thaker, H.D.; Cankaya, A.; Scott, R.W.; Tew, G.N. Role of Amphiphilicity in the Design of Synthetic Mimics of Antimicrobial Peptides with Gram-Negative Activity. ACS Med. Chem. Lett. 2013, 4, 481–485. [Google Scholar] [CrossRef] [PubMed]
- Matsuzaki, K. Control of cell selectivity of antimicrobial peptides. Biochim. Biophys. Acta BBA Biomembr. 2009, 1788, 1687–1692. [Google Scholar] [CrossRef] [PubMed] [Green Version]
- Ikeda, T.; Tazuke, S. Biologically active polycations: Antimicrobial activities of Poly[trialkyl(vinylbenzyl)ammonium chloride]-type polycations. Die Makromol. Chem. Rapid Commun. 1983, 4, 459–461. [Google Scholar] [CrossRef]
- Ikeda, T.; Tazuke, S. Synthesis and antimicrobial activity of poly (trialkylvinylbenzylammonium ch1oride) s. Synthesis 1984, 876, 869–876. [Google Scholar]
- Timofeeva, L.; Kleshcheva, N. Antimicrobial polymers: Mechanism of action, factors of activity, and applications. Appl. Microbiol. Biotechnol. 2011, 89, 475–492. [Google Scholar] [CrossRef] [PubMed]
- Gelman, M.A.; Weisblum, B.; Lynn, D.M.; Gellman, S.H. Biocidal activity of polystyrenes that are cationic by virtue of protonation. Org. lett. 2004, 6, 557–560. [Google Scholar] [CrossRef] [PubMed]
- Vigliotta, G.; Mella, M.; Rega, D.; Izzo, L. Modulating Antimicrobial Activity by Synthesis: Dendritic Copolymers Based on Nonquaternized 2-(Dimethylamino)ethyl Methacrylate by Cu-Mediated ATRP. Biomacromolecules 2012, 13, 833–841. [Google Scholar] [CrossRef] [PubMed]
- Ornelas-Megiatto, C.; Wich, P.R.; Fréchet, J.M.J. Polyphosphonium Polymers for siRNA Delivery: An Efficient and Nontoxic Alternative to Polyammonium Carriers. J. Am. Chem. Soc. 2012, 134, 1902–1905. [Google Scholar] [CrossRef] [PubMed]
- Hemp, S.T.; Smith, A.E.; Bryson, J.M.; Allen, M.H.; Long, T.E. Phosphonium-Containing Diblock Copolymers for Enhanced Colloidal Stability and Efficient Nucleic Acid Delivery. Biomacromolecules 2012, 13, 2439–2445. [Google Scholar] [CrossRef] [PubMed]
- Popa, A.; Davidescu, C.M.; Trif, R.; Ilia, G.; Iliescu, S.; Dehelean, G. Study of quaternary “onium”salts grafted on polymers: Antibacterial activity of quaternary phosphonium salts grafted on “gel-type”styrene–divinylbenzene copolymers. React. Funct. Polym. 2003, 55, 151–158. [Google Scholar] [CrossRef]
- Li, C.; Liu, Y.; Zeng, Q.Y.; Ao, N.J. Preparation and antimicrobial activity of quaternary phosphonium modified epoxidized natural rubber. Mater. Lett. 2013, 93, 145–148. [Google Scholar] [CrossRef]
- Xue, Y.; Pan, Y.; Xiao, H.; Zhao, Y. Novel quaternary phosphonium-type cationic polyacrylamide and elucidation of dual-functional antibacterial/antiviral activity. RSC Adv. 2014, 4, 46887–46895. [Google Scholar] [CrossRef]
- Sun, Y.; Sun, G. Novel Refreshable N-Halamine Polymeric Biocides: N-Chlorination of Aromatic Polyamides. Ind. Eng. Chem. Res. 2004, 43, 5015–5020. [Google Scholar] [CrossRef]
- Sun, Y.; Chen, T.-Y.; Worley, S.D.; Sun, G. Novel refreshable N-halamine polymeric biocides containing imidazolidin-4-one derivatives. J. Polym. Sci. Part A Polym. Chem. 2001, 39, 3073–3084. [Google Scholar] [CrossRef]
- Hirayama, M. The antimicrobial activity, hydrophobicity and toxicity of sulfonium compounds, and their relationship. Biocontrol Sci. 2011, 16, 23–31. [Google Scholar] [CrossRef] [PubMed]
- Ward, M.; Sanchez, M.; Elasri, M.O.; Lowe, A.B. Antimicrobial activity of statistical polymethacrylic sulfopropylbetaines against gram-positive and gram-negative bacteria. J. Appl. Polym. Sci. 2006, 101, 1036–1041. [Google Scholar] [CrossRef]
- Lowe, A.; Deng, W.; Smith, D.W.; Balkus, K.J. Acrylonitrile-Based Nitric Oxide Releasing Melt-Spun Fibers for Enhanced Wound Healing. Macromolecules 2012, 45, 5894–5900. [Google Scholar] [CrossRef]
- Hui, F.; Debiemme-Chouvy, C. Antimicrobial N-Halamine Polymers and Coatings: A Review of Their Synthesis, Characterization, and Applications. Biomacromolecules 2013, 14, 585–601. [Google Scholar] [CrossRef] [PubMed]
- Mi, L.; Jiang, S. Integrated Antimicrobial and Nonfouling Zwitterionic Polymers. Angew. Chem. Int. Ed. 2014, 53, 1746–1754. [Google Scholar] [CrossRef] [PubMed]
- Cao, Z.; Brault, N.; Xue, H.; Keefe, A.; Jiang, S. Manipulating Sticky and Non-Sticky Properties in a Single Material. Angew. Chem. 2011, 123, 6226–6228. [Google Scholar] [CrossRef]
- Cao, Z.; Mi, L.; Mendiola, J.; Ella-Menye, J.-R.; Zhang, L.; Xue, H.; Jiang, S. Reversibly Switching the Function of a Surface between Attacking and Defending against Bacteria. Angew. Chem. Int. Ed. 2012, 51, 2602–2605. [Google Scholar] [CrossRef] [PubMed]
- Engler, A.C.; Wiradharma, N.; Ong, Z.Y.; Coady, D.J.; Hedrick, J.L.; Yang, Y.Y. Emerging trends in macromolecular antimicrobials to fight multi-drug-resistant infections. Nano Today 2012, 7, 201–222. [Google Scholar] [CrossRef]
- Cheng, C.-Y.; Wang, J.-Y.; Kausik, R.; Lee, K.Y.C.; Han, S. Nature of Interactions between PEO-PPO-PEO Triblock Copolymers and Lipid Membranes: (II) Role of Hydration Dynamics Revealed by Dynamic Nuclear Polarization. Biomacromolecules 2012, 13, 2624–2633. [Google Scholar] [CrossRef] [PubMed] [Green Version]
- Palermo, E.F.; Sovadinova, I.; Kuroda, K. Structural Determinants of Antimicrobial Activity and Biocompatibility in Membrane-Disrupting Methacrylamide Random Copolymers. Biomacromolecules 2009, 10, 3098–3107. [Google Scholar] [CrossRef] [PubMed]
- Jiang, Y.; Yang, X.; Zhu, R.; Hu, K.; Lan, W.-W.; Wu, F.; Yang, L. Acid-Activated Antimicrobial Random Copolymers: A Mechanism-Guided Design of Antimicrobial Peptide Mimics. Macromolecules 2013, 46, 3959–3964. [Google Scholar] [CrossRef]
- Yang, X.; Hu, K.; Hu, G.; Shi, D.; Jiang, Y.; Hui, L.; Zhu, R.; Xie, Y.; Yang, L. Long Hydrophilic-and-Cationic Polymers: A Different Pathway toward Preferential Activity against Bacterial over Mammalian Membranes. Biomacromolecules 2014, 15, 3267–3277. [Google Scholar] [CrossRef] [PubMed]
- Oda, Y.; Kanaoka, S.; Sato, T.; Aoshima, S.; Kuroda, K. Block versus Random Amphiphilic Copolymers as Antibacterial Agents. Biomacromolecules 2011, 12, 3581–3591. [Google Scholar] [CrossRef] [PubMed]
- Correia, T.R.; Figueira, D.R.; de Sá, K.D.; Miguel, S.P.; Fradique, R.G.; Mendonça, A.G.; Correia, I.J. 3D printed scaffolds with bactericidal activity aimed for bone tissue regeneration. Int. J. Biol. Macromol. 2016, 93, 1432–1445. [Google Scholar] [CrossRef] [PubMed]
- Tardajos, M.G.; Cama, G.; Dash, M.; Misseeuw, L.; Gheysens, T.; Gorzelanny, C.; Coenye, T.; Dubruel, P. Chitosan functionalized poly-ε-caprolactone electrospun fibers and 3D printed scaffolds as antibacterial materials for tissue engineering applications. Carbohydr. Polym. 2018, 191, 127–135. [Google Scholar] [CrossRef] [PubMed] [Green Version]
- Chou, Y.-C.; Lee, D.; Chang, T.-M.; Hsu, Y.-H.; Yu, Y.-H.; Chan, E.-C.; Liu, S.-J. Combination of a biodegradable three-dimensional (3D)—Printed cage for mechanical support and nanofibrous membranes for sustainable release of antimicrobial agents for treating the femoral metaphyseal comminuted fracture. J. Mech. Behav. Biomed. Mater. 2017, 72, 209–218. [Google Scholar] [CrossRef] [PubMed]
- Muwaffak, Z.; Goyanes, A.; Clark, V.; Basit, A.W.; Hilton, S.T.; Gaisford, S. Patient-specific 3D scanned and 3D printed antimicrobial polycaprolactone wound dressings. Int. J. Pharm. 2017, 527, 161–170. [Google Scholar] [CrossRef] [PubMed] [Green Version]
- Cheng, Y.L.; Chen, F. Preparation and characterization of photocured poly (ε-caprolactone) diacrylate/poly (ethylene glycol) diacrylate/chitosan for photopolymerization-type 3D printing. Mater. Sci. Eng. C 2017, 81, 66–73. [Google Scholar] [CrossRef] [PubMed]
- Kargupta, R.; Bok, S.; Darr, C.M.; Crist, B.D.; Gangopadhyay, K.; Gangopadhyay, S.; Sengupta, S. Coatings and surface modifications imparting antimicrobial activity to orthopedic implants. Wiley Interdiscip. Rev. Nanomed. Nanobiotechnol. 2014, 6, 475–495. [Google Scholar] [CrossRef] [PubMed]
- Klemm, D.; Cranston, E.D.; Fischer, D.; Gama, M.; Kedzior, S.A.; Kralisch, D.; Kramer, F.; Kondo, T.; Lindström, T.; Nietzsche, S.; et al. Nanocellulose as a natural source for groundbreaking applications in materials science: Today’s state. Mater. Today 2018, 21, 720–748. [Google Scholar] [CrossRef]
- Sultan, S.; Siqueira, G.; Zimmermann, T.; Mathew, A.P. 3D printing of nano-cellulosic biomaterials for medical applications. Curr. Opin. Biomed. Eng. 2017, 2, 29–34. [Google Scholar] [CrossRef]
- Pattinson, S.W.; Hart, A.J. Additive Manufacturing of Cellulosic Materials with Robust Mechanics and Antimicrobial Functionality. Adv. Mater. Technol. 2017, 2, 1600084. [Google Scholar] [CrossRef] [Green Version]
- Martínez Ávila, H.; Schwarz, S.; Rotter, N.; Gatenholm, P. 3D bioprinting of human chondrocyte-laden nanocellulose hydrogels for patient-specific auricular cartilage regeneration. Bioprinting 2016, 1–2, 22–35. [Google Scholar] [CrossRef]
- Yue, J.; Zhao, P.; Gerasimov, J.Y.; Van De Lagemaat, M.; Grotenhuis, A.; Rustema-Abbing, M.; Van Der Mei, H.C.; Busscher, H.J.; Herrmann, A.; Ren, Y. 3D-Printable Antimicrobial Composite Resins. Adv. Funct. Mater. 2015, 25, 6756–6767. [Google Scholar] [CrossRef]
- Garcia, C.; Gallardo, A.; López, D.; Azzahti, A.; Lopez-Martinez, E.; Cortajarena, A.L.; Gonzalez-Henriquez, C.M.; Sarabia-Vallejos, M.A.; Rodríguez-Hernández, J. Smart pH-responsive antimicrobial hydrogel scaffolds prepared by additive manufacturing. ACS Appl. Bio Mater 2018, 1, 1337–1347. [Google Scholar] [CrossRef]
- Water, J.J.; Bohr, A.; Boetker, J.; Aho, J.; Sandler, N.; Nielsen, H.M.; Rantanen, J. Three-dimensional printing of drug-eluting implants: Preparation of an antimicrobial polylactide feedstock material. J. Pharm. Sci. 2015, 104, 1099–1107. [Google Scholar] [CrossRef] [PubMed]
- Mills, D.K.; Jammalamadaka, U.; Tappa, K.; Weisman, J. Studies on the cytocompatibility, mechanical and antimicrobial properties of 3D printed poly(methyl methacrylate) beads. Bioact. Mater. 2018, 3, 157–166. [Google Scholar] [CrossRef] [PubMed]
- Vargas-Alfredo, N.; Dorronsoro, A.; Cortajarena, A.L.; Rodríguez-Hernández, J. Antimicrobial 3D Porous Scaffolds Prepared by Additive Manufacturing and Breath Figures. ACS Appl. Mater. Interfaces 2017, 9, 37454–37462. [Google Scholar] [CrossRef] [PubMed] [Green Version]
- Vargas-Alfredo, N.; Reinecke, H.; Gallardo, A.; del Campo, A.; Rodríguez-Hernández, J. Fabrication of 3D printed objects with controlled surface chemistry and topography. Eur. Polym. J. 2018, 98, 21–27. [Google Scholar] [CrossRef] [Green Version]
- Chen, Q.; Mangadlao, J.D.; Wallat, J.; De Leon, A.; Pokorski, J.K.; Advincula, R.C. 3D printing biocompatible polyurethane/poly(lactic acid)/graphene oxide nanocomposites: Anisotropic properties. ACS Appl. Mater. Interfaces 2017, 9, 4015–4023. [Google Scholar] [CrossRef] [PubMed]
- Tiimob, B.J.; Mwinyelle, G.; Abdela, W.; Samuel, T.; Jeelani, S.; Rangari, V.K. Nanoengineered Eggshell-Silver Tailored Copolyester Polymer Blend Film with Antimicrobial Properties. J. Agric. Food Chem. 2017, 65, 1967–1976. [Google Scholar] [CrossRef] [PubMed]
- Zuniga, J. 3D Printed Antibacterial Prostheses. Appl. Sci. 2018, 8, 1651. [Google Scholar] [CrossRef]
- Totu, E.E.; Nechifor, A.C.; Nechifor, G.; Aboul-Enein, H.Y.; Cristache, C.M. Poly(methyl methacrylate) with TiO2 nanoparticles inclusion for stereolitographic complete denture manufacturing—The fututre in dental care for elderly edentulous patients? J. Dent. 2017, 59, 68–77. [Google Scholar] [CrossRef] [PubMed]

| Compounds | Available | Toxicological Information |
|---|---|---|
| Photoinitiators | ||
| Phosphine oxide compounds 1 | FORMlabs (Dental and E-Shell series) | Fertility-impairing effect [20], acute and chronic toxic for aquatic organisms [21], toxic effect on mouse NIH 3T3 cells [22]. Not readily biodegradable by Organization for Economic Cooperation and Development (OECD) criteria [21,23,24]. |
| Benzophenone compounds 2 | UV-cured inks | Causes liver hypertrophy and kidney adenoma in rats [25,26]. |
| Triarylsulfonium salt (Cationic) 3 | 3D Systems | EC50 (24 h) Daphnia magna—4.4 mg/L [27]. EC50 (48 h) Daphnia magna—0.68 mg/L [27]. |
| Photopolymers | ||
| Acrylate monomers, Acrylate and Urethane acrylate oligomers | FORMlabs Autodesk Envisiontec 3D Systems | Toxic or harmful to various species of fish, algae, and water microorganisms [23]. Potential mutagens and a reproductive and developmental toxicant [28,29]. |
| Methyl methacrylate monomers 3 and oligomers | FORMlabs (Envisiontec Dental resin) | Assessment of repeated dose toxicity indicates the potential to affect the liver and kidneys, as indicated in animal studies [30]. Potential mutagen, and a reproductive and developmental toxicant, aquatic toxicant, and genotoxic in mammalian cell culture [31,32,33]. |
| Bisphenol A-diglycidyl dimethacrylate (Bis-GMA) | Dental resins | EC50 mouse fibroblast—9.35 μM [34]. |
| Auxiliary compounds | ||
| Butylated hydroxytoluene | Dental resins | Toxic or harmful to various species of fish, algae, and water microorganisms [35]. |
| Sebacate compounds 4 | FORMlabs (Dental Envisiontec) | Toxic to aquatic life with long-lasting effects [23], not readily biodegradable (OECD 301B) [23,36]. |
| Hydroquinone | Dental resins | Evidence of mutagenicity in mammal studies, toxic to aquatic life; absorption, in sufficient concentrations, leads to cyanosis [37]. |
© 2019 by the authors. Licensee MDPI, Basel, Switzerland. This article is an open access article distributed under the terms and conditions of the Creative Commons Attribution (CC BY) license (http://creativecommons.org/licenses/by/4.0/).
Share and Cite
González-Henríquez, C.M.; Sarabia-Vallejos, M.A.; Rodríguez Hernandez, J. Antimicrobial Polymers for Additive Manufacturing. Int. J. Mol. Sci. 2019, 20, 1210. https://doi.org/10.3390/ijms20051210
González-Henríquez CM, Sarabia-Vallejos MA, Rodríguez Hernandez J. Antimicrobial Polymers for Additive Manufacturing. International Journal of Molecular Sciences. 2019; 20(5):1210. https://doi.org/10.3390/ijms20051210
Chicago/Turabian StyleGonzález-Henríquez, Carmen Mabel, Mauricio A. Sarabia-Vallejos, and Juan Rodríguez Hernandez. 2019. "Antimicrobial Polymers for Additive Manufacturing" International Journal of Molecular Sciences 20, no. 5: 1210. https://doi.org/10.3390/ijms20051210
APA StyleGonzález-Henríquez, C. M., Sarabia-Vallejos, M. A., & Rodríguez Hernandez, J. (2019). Antimicrobial Polymers for Additive Manufacturing. International Journal of Molecular Sciences, 20(5), 1210. https://doi.org/10.3390/ijms20051210






